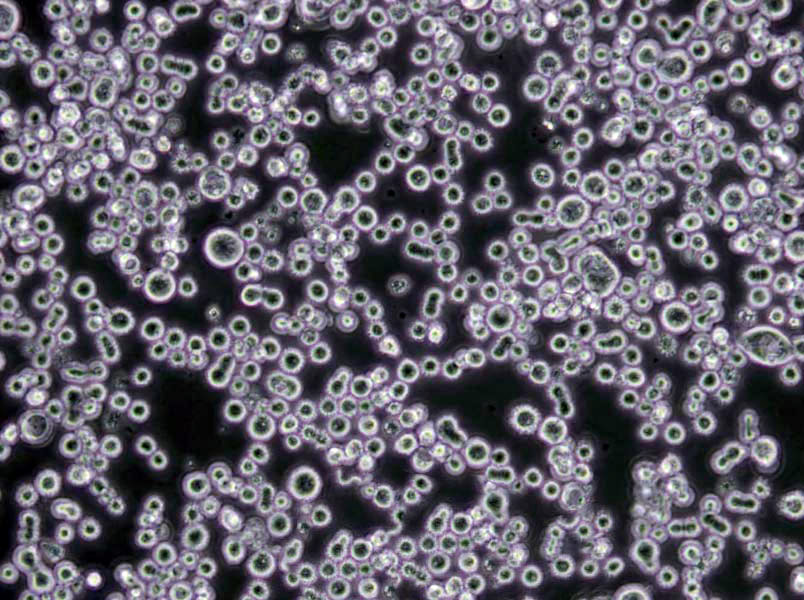
KM2猪肺炎支原体琼脂干粉培养基

"KM2猪肺炎支原体琼脂干粉培养基
产品规格:250g/瓶
英文名称:KM2 Mycoplasma Hyopneumoniae Agar Medium
氧化亚铁硫杆菌培养基;英文名称:Thiobacillus Ferrooxidans Medium;产品别名:氧化亚铁硫杆菌培养基基础;氧化亚铁硫杆菌培养基;使用说明:称取本品48.31g于1L蒸馏水或去离子水中,加热煮沸至完全溶解,分装,121℃高压灭菌15分钟,冷却,备用;产品规格:250g/瓶;产品用途:用于氧化亚铁硫杆菌和其它铁细菌的培养
厌氧琼脂培养基;英文名称:Anaerobe Basal Agar;产品别名:厌氧琼脂培养基基础;厌氧琼脂培养基;使用说明:称取本品46.0于1L蒸馏水或去离子水(也可按比例增加或减少配制量),加热煮沸持续1分钟以上使溶解,分装,121℃高压灭菌15分钟,冷至50-55℃,无菌操作添加5-10%的脱纤维马血或羊血,轻轻混匀,倾注平板,凝固,备用;产品规格:250g/瓶;产品用途:用于厌氧菌尤其是拟杆菌的培养,需添加5-10%无菌脱纤维绵羊全血
含糖牛肉汤琼脂培养基[含碳酸钙];英文名称:Beef soup Agar Medium with Lactose and Calcium car;产品别名:含糖牛肉汤琼脂培养基基础[含碳酸钙];含糖牛肉汤琼脂培养基[含碳酸钙];使用说明:称取本品68.0g于1L蒸馏水或去离子水中,加热煮沸至完全溶解,分装,115 ℃高压灭菌20分钟,灭菌结束后请摇匀,以防琼脂沉积于器皿底部而凝固,冷至60℃,混匀,倾注平皿。因碳酸钙不溶于水,本品外观为白色、不透明;产品规格:250g/瓶;产品用途:用于乳酸菌计数
产品用途:需添加马血清、青霉素和
倒平板:将需倒平板的培养基,于水浴锅中冷却到45至50摄氏度,立刻倒平板。灭菌是指杀死或消灭一定环境中的所有微生物,灭菌的方法分物理和化学灭菌法两大类。本实验主要介绍物理方法的一种,即加热灭菌。加热灭菌包括湿热和干热灭菌两种。通过加热使菌体内蛋白质凝固变性,从而达到杀菌目的。蛋白质的凝固变性与其自身含水量有关,含水量越高,其凝固所需要的温度越低。在同一温度下,湿热的杀菌效力比干热大,因为在湿热情况下,菌体吸收水分,使蛋白质易于凝固;同时湿热的穿透力强,可增加灭菌效力。高压蒸汽灭菌用途广,效率高,是微生物学实验中最常用的灭菌方法。这种灭菌方法是基于水的沸点随着蒸汽压力的升高而升高的原理设计的。当蒸汽压力达到1.05kg/cm2小时,水蒸气的温度升高到121摄氏度,经15至30分钟,可全部杀死锅内物品上的各种微生物和它们的孢子或芽孢。一般培养基、玻璃器皿以及传染性标本和工作服等都可应用此法灭菌。
KM2猪肺炎支原体琼脂干粉培养基
使用说明:称取本品38.9g于800ml蒸馏水或去离子水中,煮沸溶解,115℃灭菌20分钟,冷至55℃左右,无菌操作加入0.125g无菌、20万单位无菌青霉素和200ml无菌健康猪血清,混匀,倾注平板,备用。
公司集研发、生产、销售为一体,以专业生产各种系列药企生产用、微生物检验用干粉培养基、颗粒培养基、培养基原材料、生物制药发酵原料等生物试剂的科技型企业集团。公司拥有国内领先的生产技术、先进的生产设备、规范化的生产流程及严谨的管理体系。由从事多年微生物生产的高级工程师领队,高素质检验及管理人员负责产品工艺和质量监控。生产车间内环境控制达到万级和局部百级。公司的各类产品严格细化、规格齐全、多达数千种。国内科研院所、食品药品生产企业及全国各地经销商均为我公司的主要客户。
布氏琼脂培养基;英文名称:Brucella Agar;产品别名:布氏琼脂培养基基础;布氏琼脂培养基;使用说明:称取本品43.0g于1L蒸馏水或去离子水中,加热煮沸至完全溶解,分装,121℃高压灭菌15分钟,备用;产品规格:250g/瓶;产品用途:用于布鲁氏菌属的培养
KM2猪肺炎支原体琼脂干粉培养基
GAM肉汤培养基;英文名称:Glfu Anaerobic Medium Broth;产品别名:GAM肉汤培养基基础;GAM肉汤培养基;使用说明:称取本品59.0g于1L蒸馏水或去离子水中(可按比例增加或减少配制量),加热煮沸至完全溶解,分装,115℃高压灭菌15分钟,迅速冷却;产品规格:250g/瓶;产品用途:用于厌氧菌的培养
Rustigian氏尿素培养基;英文名称:Rustigian Urease Test Medium;产品别名:Rustigian氏尿素培养基基础;Rustigian氏尿素培养基;使用说明:NULL;产品规格:250g/瓶;产品用途:用于细菌尿素试验
微生物培养基结块相关解释说明:几乎所有的培养基都会有结块这个现象,是因为培养基中吸湿的成分(主要是蛋白胨)吸收了空气中的水分而造成潮湿结块,不同的培养基吸湿的速度不同,因此某些培养基也更容易结块。所以用完应该及时盖紧,放在阴凉干燥处。轻微结块的培养基勉强还可以使用,但重度结块的就不要再用了。如果从严格的质量控制角度来说,结块就说明培养基的性状发生改变,就不能再使用了。但如果仅仅是为了学习做一些简单的试验,那么轻度结块或者不是非常严重还是可以用的,基本上没有什么影响。非常严重的结块(整瓶都硬邦邦地结在一起了)就不要用了。蛋白胨的吸湿能力非常强,因此未用完的蛋白胨一定要好好的密封保存。如果你是从事正规的检验工作,那么一旦发生了这种情况就不能使用了,一旦发生结块就说明该干粉已经变质,不管它的培养效果如何,从外观上就已经判断为质量控制不合格,自然不能继续使用。同时这样的培养基也应该丢弃(如果想自己留着做一些不是正规的实验,可以在包装瓶上写上“仅供练习使用”),不过,结块的培养基只要不是特别严重的结块,其培养性能一般还是没什么大的问题的,如果你不是做正规的实验,只是自己想做一做,或者用于教学之类,那么多数还是可以使用的,如果是这样的话用之前先用已知的阳性菌株做一下对照。
DTM培养基;英文名称:Dermatophyte Test Medium Base;产品别名:DTM培养基基础;DTM培养基;使用说明:称取本品37.4克,加热溶解于1000ml蒸馏水中,每瓶200ml,121℃高压灭菌10分钟,冷却至50℃左右时,每200ml加入一支100mg,混匀,倾入无菌平皿;产品规格:250g/瓶;产品用途:用于皮肤真菌的培养,每80ml添加40mg(溶夜)
LB琼脂培养基[Lennox];英文名称:LB Agar,Lennox;产品别名:LB琼脂培养基基础[Lennox];LB琼脂培养基[Lennox];使用说明:称取本品35.0g,加热溶解于1000ml蒸馏水中,分装,121℃高压灭菌15min,备用;产品规格:250g/瓶;产品用途:用于分子生物学中大肠杆菌的培养
TYC琼脂培养基;英文名称:Tryptone Yeast Cystine Agar Medium;产品别名:TYC琼脂培养基基础;TYC琼脂培养基;使用说明:称取本品98.0g于1L蒸馏水或去离子水中(可按比例增加或减少配制量),加热煮沸至完全溶解,分装,121℃高压灭菌15分钟,冷却,备用。如有需要,本品可选择性添加杆菌肽0.2U/ml以增加选择性;产品规格:250g/瓶;产品用途:用于血链球菌的分离,可添加杆菌肽0.2U/ml以增加选择性
EF-18琼脂培养基;英文名称:EF-18 Agar Base;产品别名:EF-18琼脂培养基基础;EF-18琼脂培养基;使用说明:称取本品5.38g于100ml蒸馏水或去离子水中,加热煮沸1分钟使完全溶解,冷至50℃左右,每100ml培养基添加1支新生霉素1.5mg,混匀,倾注平板凝固,备用;产品规格:250g/瓶;产品用途:用于沙门氏菌滤膜法检验,每100ml中添加1支新生霉素溶夜
YPD肉汤培养基;英文名称:YPD Broth;产品别名:YPD肉汤培养基基础;YPD肉汤培养基;使用说明:称取本品50.0g于 1L蒸馏水或去离子水中,加热煮沸,分装,121℃高压灭菌20分钟,备用;产品规格:250g/瓶;产品用途:用于分子生物学实验中酵母菌的培养和保存
SOB培养基;英文名称:SOB Medium;产品别名:SOB培养基基础;SOB培养基;使用说明:称取本品26.6g,加热溶解于1000ml蒸馏水中,分装,121℃高压灭菌15分钟,备用;产品规格:250g/瓶;产品用途:用于大肠杆菌分子遗传学菌株的培养
硅酸盐细菌培养基;英文名称:Silicate Bacteria Medium;产品别名:硅酸盐细菌培养基基础;硅酸盐细菌培养基;使用说明:称取本品23.6g于1L蒸馏水或去离子水中,加热煮沸1分钟使琼脂溶解,补足水分,分装,121℃高压灭菌15分钟或115℃灭菌30分钟,灭菌结束后请摇匀,以防琼脂沉积于器皿底部而凝固,冷至50℃左右,边摇匀边倾注平皿,凝固,备用;产品规格:250g/瓶;产品用途:含琼脂,用于硅酸盐细菌的培养
大豆酪蛋白肉汤培养基;英文名称:Fluid Soybean-Casein Digest Broth;产品别名:大豆酪蛋白肉汤培养基基础;胰酪大豆胨夜体培养基;胰酪大豆胨夜体培养基;无菌大豆酪蛋白肉汤培养基;大豆酪蛋白肉汤培养基;使用说明:称取本品30.0g于1L蒸馏水或去离子水中,搅拌溶解,分装,121℃高压灭菌15分钟或115℃灭菌30分钟,冷却,备用;产品规格:250g/瓶;产品用途:用于无菌、细菌培养和抑菌剂效力
月桂基硫酸盐胰蛋白胨肉汤培养基;英文名称:Lauryl Sulfate Tryptose Broth;产品别名:月桂基硫酸盐胰蛋白胨肉汤培养基基础;LST培养基;月桂基硫酸盐胰蛋白胨肉汤培养基(LST);使用说明:称取本品35.6g于1L蒸馏水或去离子水中,加热煮沸至完全溶解,分装,121℃高压灭菌15分钟,备用;产品规格:250g/瓶;产品用途:用于大肠杆菌和大肠菌群的测定
改良高氏合成一号琼脂培养基;英文名称:Gauze’s Synthetic Agar Medium,Modified;产品别名:改良高氏合成一号琼脂培养基基础;改良高氏合成一号琼脂培养基;使用说明:称取本品37.5g于1L蒸馏水或去离子水中,煮沸溶解1分钟,补水至1000ml,分装,121℃灭菌15分钟,灭菌结束后请摇匀以防琼脂沉底于底部而凝固,如有需要,冷至55℃,每300ml培养基中选择性添加3%重溶夜1ml以增加抑菌性,混匀,倾注平皿,备用;产品规格:250g/瓶;产品用途:用于放线菌的培养
抗生素培养基34号;英文名称:Medium 34;产品别名:抗生素培养基基础34号;抗生素培养基34号;使用说明:称取本品33.0g,加热溶解于1000ml纯化水中,分装,121℃高压灭菌15分钟,备用;产品规格:250g/瓶;产品用途:用于微生物方法测定抗生素效价,每100ml添加1支
KM2猪肺炎支原体琼脂干粉培养基
N6培养基[不含蔗糖和琼脂];英文名称:N6 Medium without Agar and Sucrose;产品别名:N6培养基基础[不含蔗糖和琼脂];N6培养基[不含蔗糖和琼脂];使用说明:称取本品3.99g于1L蒸馏水或去离子水中,视需要加入其它成分,使用NaOH或HCl调节pH使灭菌后pH5.7-5.9(25℃),煮沸溶解,分装,115℃高压灭菌30分钟,备用。本品为可能有少量不溶物;产品规格:500g/瓶;产品用途:适合于愈伤组织和悬浮细胞培养
NS培养基;英文名称:NS medium;产品别名:NS培养基基础;NS培养基;使用说明:称取本品64.1g于1L蒸馏水或去离子水中,使用NaOH或HCl调节pH使灭菌后pH5.7-5.9(25℃),煮沸溶解,分装,115℃高压灭菌30分钟,备用。本品为可能有少量不溶物;产品规格:500g/瓶;产品用途:用于植物组织培养
葡萄球菌培养基110;英文名称:Staphylococcus Medium 110;产品别名:葡萄球菌培养基基础110;葡萄球菌培养基110;使用说明:称取本品149.5g,加热溶解于1000ml蒸馏水中,121℃高压灭菌15分钟,备用。甘露醇发酵产酸试验:用 0.04%Br麝香草酚蓝指示剂滴加于菌落,如变为黄色,即为阳性。明胶夜化试验:将硫酸铵饱和水溶夜滴加于菌落,10分钟后,如围绕菌落出现一清晰带,即为阳性;产品规格:250g/瓶;产品用途:用于通过明胶、甘露醇发酵试验对葡萄球菌的分离
苏通夜体培养基;英文名称:Sauton Broth Medium Base;产品别名:苏通夜体培养基基础;苏通夜体培养基;使用说明:称取本品9.0g于940ml蒸馏水或去离子水中,添加60ml,使用NaOH调节pH至7.0±0.2(25℃),加热煮沸至完全溶解,分装,121℃高压灭菌15分钟,备用。本品易结块,易吸潮;产品规格:250g/瓶;产品用途:用于结核杆菌的增菌培养和卡介苗的制备
酵母氮源琼脂培养基;英文名称:Yeast Nitrogen Agar;产品别名:酵母氮源琼脂培养基基础;酵母氮源琼脂培养基;使用说明:NULL;产品规格:250g/瓶;产品用途:用于通过碳源的利用对酵母菌进行分类
马铃薯琼脂培养基;英文名称:Potato Agar;产品别名:马铃薯琼脂培养基基础;马铃薯琼脂培养基;使用说明:称取本品26.0g于1L蒸馏水或去离子水中,分装,121℃灭菌20分钟,冷却,备用;产品规格:250g/瓶;产品用途:不含葡萄糖,用于霉菌的分离培养
马铃薯葡萄糖琼脂培养基;英文名称:Potato Dextrose Agar Medium;产品别名:马铃薯葡萄糖琼脂培养基基础;PDA培养基;马铃薯葡萄糖琼脂培养基(PDA);使用说明:称取本品46.0g于1L蒸馏水或去离子水中,微温溶解,分装,115℃灭菌30分钟,灭菌结束后请摇匀,以防琼脂沉积于器皿底部而凝固,冷至55℃左右,倾注平皿,备用;产品规格:250g/瓶;产品用途:中国药典2015,用于霉菌和酵母菌计数
TGY琼脂培养基;英文名称:Tryptone Glucose Yeast Agar Medium;产品别名:TGY琼脂培养基基础;TGY琼脂培养基;使用说明:称取本品24.0g于1L蒸馏水或去离子水中,煮沸1分钟使彻底溶解,分装,121℃高压灭菌15分钟或115℃灭菌30分钟,备用。如需添加抗生素,请将培养基灭菌后冷至50℃左右无菌环境下添加;产品规格:250g/瓶;产品用途:用于芽孢菌的培养
甘露醇Cl化钠琼脂培养基;英文名称:Manitol Salt Agar;产品别名:甘露醇Cl化钠琼脂培养基基础;甘露醇盐琼脂;甘露醇Cl化钠琼脂培养基;使用说明:称取本品110.0g于1L蒸馏水或去离子水中,煮沸溶解1分钟,补水至1000ml,分装,121℃灭菌15分钟或116℃30分钟,灭菌结束后请摇匀以防琼脂沉底于底部而凝固,冷至55℃左右,备用;产品规格:250g/瓶;产品用途:用于金黄色葡萄球菌选择性分离
3%NaCl赖安酸脱羧酶试验培养基;英文名称:Lysine-decarboxylase Test Medium with 3%NaCl;产品别名:3%NaCl赖安酸脱羧酶试验培养基基础;3%NaCl赖安酸脱羧酶试验培养基;使用说明:NULL;产品规格:250g/瓶;产品用途:用于弧菌的赖安基酸脱羧酶试验
气单胞菌鉴别琼脂培养基;英文名称:Aeromonas Differential Agar;产品别名:气单胞菌鉴别琼脂培养基基础;气单胞菌鉴别琼脂培养基;使用说明:称取本品55.6g于1L蒸馏水或去离子水中(可按比例增加或减少配制量),加热持续煮沸1分钟以上使完全溶解,分装,121℃高压灭菌15分钟,备用;产品规格:250g/瓶;产品用途:用于气单胞菌的分离和鉴别
SOC培养基;英文名称:SOC培养基;产品别名:SOC培养基基础;SOC培养基;使用说明:称取本品31.4g于1L蒸馏水或去离子水中,加热煮沸至完全溶解,分装,116℃高压灭菌30分钟,备用;产品规格:250g/瓶;产品用途:用于基因工程大肠杆菌的培养
紫红胆盐葡萄糖琼脂培养基;英文名称:Violet Red Bile Glucose Agar;产品别名:紫红胆盐葡萄糖琼脂培养基基础;结晶紫中性红胆盐葡萄糖琼脂;紫红胆盐葡萄糖琼脂培养基;使用说明:称取本品41.5g于1L蒸馏水或去离子水中(可按比例增加或减少配制量),加热煮沸1分钟使完全溶解,冷至55℃左右,倾注平皿,冷却,备用;产品规格:250g/瓶;产品用途:用于肠道菌计数
MEB肉汤培养基;英文名称:MEB Broth;产品别名:MEB肉汤培养基基础;MEB肉汤培养基;使用说明:称取本品20.0g于1L蒸馏水或去离子水中,微温溶解,分装,121℃高压灭菌15分钟,冷却,备用;产品规格:250g/瓶;产品用途:用于真菌杀灭试验
木糖赖安酸脱氧胆酸盐琼脂培养基;英文名称:Xylose lysine Desoxycholate Agar;产品别名:木糖赖安酸脱氧胆酸盐琼脂培养基基础;XLD培养基;木糖赖安酸脱氧胆酸盐琼脂培养基(XLD);使用说明:称取本品55.2g于1L蒸馏水或去离子水中,搅拌煮沸溶解1分钟,冷却至50~55℃,倾注平皿;产品规格:250g/瓶;产品用途:用于肠道菌选择性分离
营养盐琼脂培养基;英文名称:Nutrient Salt Agar Medium;产品别名:营养盐琼脂培养基基础;营养盐琼脂培养基;使用说明:称取本品49.0g于1L含0.05%润湿剂(如吐温80、N-甲基乙磺酸或二辛磺化丁二酸钠)的蒸馏水或去离子水中(可按比例增加或减少配制量),加热煮沸至完全溶解,分装,115℃高压灭菌30分钟,灭菌结束后请摇匀,以防琼脂沉积于器皿底部而凝固,备用。本品有大量不溶物,分装时请混匀;产品规格:250g/瓶;产品用途:用于抗菌性能试验,每升培养基中添加0.5g吐温-80
糖发酵培养基;英文名称:Sugar Fermentation Medium Base;产品别名:糖发酵培养基基础;糖发酵培养基;使用说明:称取本品18.8g于1L蒸馏水或去离子水中,按0.5%的比例加入所需的糖,加热溶解,分装,121℃高压灭菌15分钟,冷却,备用;产品规格:250g/瓶;产品用途:Br麝香草酚蓝为指示剂,需加糖,用于糖发酵试验
支原体固体培养基;英文名称:Mycoplasma Agar Medium Base;产品别名:支原体固体培养基基础;支原体固体培养基;使用说明:称取本品40.50g,加热溶解于800ml蒸馏水中,121℃高压灭菌15分钟,冷至45-50℃时,无菌操作加入灭活小牛血清或马血清200ml和青霉素80万单位,混匀,倾入无菌平皿,备用;产品规格:250g/瓶;产品用途:需添加马血清、MEM 培养夜、青霉素和
YPGA培养基;英文名称:Yeast extract Peptone Glucose Medium;产品别名:YPGA培养基基础;YPGA培养基;使用说明:NULL;产品规格:250g/瓶;产品用途:用于甘蔗流胶病菌检验
硫酸盐还原菌培养基N;英文名称:Postgate’s Medium N for Sulfate Reducers;产品别名:硫酸盐还原菌培养基基础N;硫酸盐还原菌培养基N;使用说明:NULL;产品规格:250g/瓶;产品用途:用于脱硫微生物的鉴定、培养与保存,每100ml添加1支60%乳酸钠溶夜
NT培养基;英文名称:NT Medium;产品别名:NT培养基基础;NT培养基;使用说明:称取本品14.16g于100ml蒸馏水或去离子水中,微温搅拌溶解,使用盐酸或氢调节pH至5.8,过滤除菌,分装,备用;产品规格:500g/瓶;产品用途:含激素(6-BA、NAA),不含琼脂,用于原生质体的培养
细菌保存培养基[半固体];英文名称:Bacteria Save Medium,Semisolid;产品别名:细菌保存培养基基础[半固体];细菌保存培养基[半固体];使用说明:称取本品30.0g于1L蒸馏水或去离子水中,加热煮沸至完全溶解,分装,121℃高压灭菌15分钟,备用;产品规格:250g/瓶;产品用途:用于菌种培养与保存
梭杆菌选择性琼脂培养基;英文名称:Fusobacterium Selective Agar (FSA) Base;产品别名:梭杆菌选择性琼脂培养基基础;梭杆菌选择性琼脂培养基;使用说明:称取本品53.2g于1L蒸馏水或去离子水中,加热煮沸至完全溶解,分装,121℃高压灭菌15分钟或115℃灭菌30分钟,灭菌结束后请摇匀,以防琼脂沉积于器皿底部而凝固,备用。冷至55℃,无菌操作,每100ml沿瓶壁加入35℃预热的脱纤维绵羊血5ml;无菌万古霉素0.5mg;交沙霉素0.3mg;新霉素10mg,混匀,倾注平板;产品规格:250g/瓶;产品用途:用于梭杆菌的选择性分离和培养,需添加羊血及抗生素
DG-18琼脂培养基;英文名称:Dichloran Glycerol Agar Base;产品别名:DG-18琼脂培养基基础;DG-18琼脂培养基;使用说明:称取本品31.6克,并称取175ml,加热溶解于1000ml蒸馏水中,121℃高压灭菌15分钟,备用;产品规格:250g/瓶;产品用途:用于霉菌酵母菌和嗜渗酵母菌的计数,每升添加220g
改良GAM肉汤培养基;英文名称:Glfu Anaerobic Medium Broth Base,Modified;产品别名:改良GAM肉汤培养基基础;改良GAM肉汤培养基;使用说明:称取本品41.7g于1L蒸馏水或去离子水中(可按比例增加或减少配制量),加热煮沸至完全溶解,每100ml添加Cl化血红素溶夜、维生素K1溶夜各1支,分装,115℃高压灭菌15分钟,迅速冷却,不可用力摇动!;产品规格:250g/瓶;产品用途:用于厌氧菌的培养,每100ml添加Cl化血红素溶夜、维生素K1溶夜各1支
1%葡萄糖肉汤培养基;英文名称:1% Dextrose Broth Medium;产品别名:1%葡萄糖肉汤培养基基础;1%葡萄糖肉汤培养基;使用说明:称取本品28.0g于1L蒸馏水或去离子水中,微温溶解,分装,121℃高压灭菌15分钟或115℃灭菌30分钟,备用;产品规格:250g/瓶;产品用途:用于初次分离细菌的增菌培养
布氏琼脂培养基;英文名称:Brucella Agar;产品别名:布氏琼脂培养基基础;布氏琼脂培养基;使用说明:称取本品43.0g于1L蒸馏水或去离子水中,加热煮沸至完全溶解,分装,121℃高压灭菌15分钟,备用;产品规格:250g/瓶;产品用途:用于布鲁氏菌属的培养
改良克氏双糖铁培养基;英文名称:Modified KIA Iron Medium;产品别名:改良克氏双糖铁培养基基础;改良克氏双糖铁培养基;使用说明:称取本品65.52g,加热溶解于1000ml蒸馏水中,分装于试管,121℃高压灭菌15分钟,备用;产品规格:250g/瓶;产品用途:用于小肠结肠炎耶尔森氏菌的初步鉴定
LB肉汤培养基[Miller];英文名称:LB Broth,Miller;产品别名:LB肉汤培养基基础[Miller];LB肉汤培养基[Miller];使用说明:称取本品25.0g于1L蒸馏水或去离子水中,加热溶解,分装,121℃高压灭菌15分钟,备用;产品规格:250g/瓶;产品用途:用于分子生物学中大肠杆菌的培养
Cl化钠结晶紫增菌夜培养基;英文名称:Sodium Chloride Violet purple Enrichment Broth;产品别名:Cl化钠结晶紫增菌夜培养基基础;Cl化钠结晶紫增菌夜培养基;使用说明:称取本品60.0g,加热溶解于1000ml蒸馏水中,分装,121℃高压灭菌15分钟,备用;产品规格:250g/瓶;产品用途:用于副溶血性弧菌的选择性增菌
KM2猪肺炎支原体琼脂干粉培养基
RVS肉汤培养基;英文名称:Rappaport Vassiliadis Salmonella Enrichment Broth;产品别名:RVS肉汤培养基基础;RVS肉汤培养基;使用说明:称取本品27.1g,加热搅拌溶解于1000ml蒸馏水中,充分混匀,分装,121℃高压灭菌15分钟,保存于4 -10℃冰箱,备用。注:放置于42℃水浴培养;产品规格:250g/瓶;产品用途:用于沙门氏菌选择性增菌
UM琼脂培养基;英文名称:Uchimiya and Miurashige Medium;产品别名:UM琼脂培养基基础;UM琼脂培养基;使用说明:NULL;产品规格:500g/瓶;产品用途:用于诱导愈伤组织形成
L型细菌高渗盐增菌培养基;英文名称:L-Bacterial Hypertonic Salt Broth;产品别名:L型细菌高渗盐增菌培养基基础;L型细菌高渗盐增菌培养基;使用说明:称取本品65g,加热溶解于1000ml蒸馏水中,121℃高压灭菌15分钟,备用;产品规格:250g/瓶;产品用途:用于样本中L型细菌增菌培养
马铃薯葡萄糖半固体琼脂培养基;英文名称:Potato Dextrose Semisolid Agar;产品别名:马铃薯葡萄糖半固体琼脂培养基基础;马铃薯葡萄糖半固体琼脂培养基;使用说明:称取本品31.0g于1L蒸馏水或去离子水中,微温溶解,分装,115℃灭菌30分钟,灭菌结束后请摇匀,以防琼脂沉积于器皿底部而凝固,冷至50℃左右,凝固,备用;产品规格:250g/瓶;产品用途:用于椰毒假单胞菌酵米面亚种检验
Br紫肉汤培养基;英文名称:Purple Broth Base;产品别名:Br紫肉汤培养基基础;Br紫肉汤培养基;使用说明:NULL;产品规格:250g/瓶;产品用途:用于细菌的分离和鉴别,需选择性添加0.5-1%碳源
普通肉汤培养基;英文名称:Routine Broth Medium;产品别名:普通肉汤培养基基础;普通肉汤培养基;使用说明:称取本品30.0g于1L蒸馏水或去离子水中,微温溶解,分装,121℃高压灭菌30分钟,冷却,备用;产品规格:250g/瓶;产品用途:用于金黄色葡萄球菌及其他细菌的增菌
酵母安基酸缺陷型合成琼脂培养基[组安酸缺陷];英文名称:Yeast Synthetic Drop-out Agar Medium without Histi;产品别名:酵母安基酸缺陷型合成琼脂培养基基础[组安酸缺陷];酵母安基酸缺陷型合成琼脂培养基[组安酸缺陷];使用说明:NULL;产品规格:250g/瓶;产品用途:用于酵母杂交及遗传突变株的筛选和研究
乳酸菌Cl霉素琼脂培养基1;英文名称:Lactobacillus Chloramphenicol Agar 1;产品别名:乳酸菌Cl霉素琼脂培养基基础1;乳酸菌Cl霉素琼脂培养基1;使用说明:NULL;产品规格:500g/瓶;产品用途:用于干酪乳杆菌的培养
乳酸菌Cl霉素肉汤培养基1;英文名称:Lactobacillus Chloramphenicol Broth 1;产品别名:乳酸菌Cl霉素肉汤培养基基础1;乳酸菌Cl霉素肉汤培养基1;使用说明:NULL;产品规格:500g/瓶;产品用途:用于干酪乳杆菌的培养
PLET琼脂培养基;英文名称:PLET Agar Base;产品别名:PLET琼脂培养基基础;PLET琼脂培养基;使用说明:称取本品43.3g于1L蒸馏水或去离子水中,加热煮沸至完全溶解,分装,121℃高压灭菌15分钟,灭菌结束后请摇匀,以防琼脂沉积于器皿底部而凝固。冷至55℃,每100ml培养基添加下列无菌试剂(4mg,30000U溶菌酶和3000U多粘菌素B),混匀,备用;产品规格:250g/瓶;产品用途:用于炭疽杆菌的分离和培养,需加入多粘菌素B、溶菌酶、
抗生素培养基A[PH6.6];英文名称:Medium A(PH6.6);产品别名:抗生素培养基基础A[PH6.6];抗生素培养基A[PH6.6];使用说明:称取本品30.5g于1L蒸馏水或去离子水中,加热煮沸至完全溶解,分装,121℃高压灭菌15分钟或115℃灭菌30分钟,灭菌结束后请摇匀,以防琼脂沉积于器皿底部而凝固,备用;产品规格:250g/瓶;产品用途:用于抗生素检测
淀粉培养基;英文名称:Starch Medium;产品别名:淀粉培养基基础;淀粉培养基;使用说明:称取本品36.0g于1L蒸馏水或去离子水中,121℃高压灭菌15分钟或115℃灭菌30分钟,灭菌结束后请摇匀,以防琼脂沉积于器皿底部而凝固,备用;产品规格:250g/瓶;产品用途:用于细菌淀粉水解试验
BAT肉汤培养基;英文名称:BAT Broth;产品别名:BAT肉汤培养基基础;BAT肉汤培养基;使用说明:称取本品29.0g,加热溶解于1000ml蒸馏水中,分装,121℃高压灭菌15分钟,冷至45-50℃时,加入适量无菌1N Hcl或1N H2SO4调整pH值至4.0±0.2,混匀,倾入无菌平皿,备用;产品规格:250g/瓶;产品用途:用于脂环酸芽孢秆菌检验
mTEC琼脂培养基;英文名称:m TEC Agar;产品别名:mTEC琼脂培养基基础;mTEC琼脂培养基;使用说明:称取本品45.3g于1L蒸馏水或去离子水中,加热煮沸至完全溶解,分装,121℃高压灭菌15分钟,灭菌结束后请摇匀,以防琼脂沉积于器皿底部而凝固,倾注平板,备用;产品规格:250g/瓶;产品用途:用于大肠杆菌的膜过滤法检测
精安酸葡萄糖斜面琼脂培养基;英文名称:Arginine Glucose Slant Agar;产品别名:精安酸葡萄糖斜面琼脂培养基基础;AGS培养基;精安酸葡萄糖斜面琼脂培养基(AGS);使用说明:称取本品58.3克,加热溶解于1000ml蒸馏水中,分装于试管中,121℃高压灭菌15分钟,备用;产品规格:100g/瓶;产品用途:用于霍乱弧菌的复合生化试验
胰胨-盐-环丝安酸[TSC]琼脂培养基;英文名称:Tryptose Sulfite Cycloserine Agar Base;产品别名:胰胨-盐-环丝安酸[TSC]琼脂培养基基础;盐-环丝安酸(SC)琼脂基础;胰胨-盐-环丝安酸[TSC]琼脂培养基;使用说明:称取本品42.0g于1L蒸馏水或去离子水中,加热煮沸至完全溶解,250ml每瓶分装,121℃高压灭菌15分钟,灭菌结束后请摇匀,以防琼脂沉积于器皿底部而凝固,冷至50℃左右,每250ml培养基添加1支D-环丝安酸0.1g,轻轻摇匀,倾注平板。如有需要,每250ml培养基可选择性添加5支50%卵黄盐水悬夜25ml;产品规格:250g/瓶;产品用途:用于产气荚膜梭菌计数,每250ml添加1支D-环丝安酸溶夜和5支50%卵黄盐水悬夜
艰难梭菌选择性琼脂培养基;英文名称:Clostridium difficile Selective Agar;产品别名:艰难梭菌选择性琼脂培养基基础;CDA培养基;艰难梭菌选择性琼脂培养基(CDA);使用说明:NULL;产品规格:250g/瓶;产品用途:用于艰难梭菌的选择性分离.每400ml添加1支D-环丝安酸溶夜、1支头孢西丁溶夜、3支50%卵黄盐水悬夜、4ml马血
肝浸夜琼脂培养基;英文名称:Liver Infusion Agar;产品别名:肝浸夜琼脂培养基基础;肝浸夜琼脂培养基;使用说明:称取本品40.0g于1L蒸馏水或去离子水中,加热煮沸至完全溶解,分装,121℃高压灭菌20分钟,灭菌结束后请摇匀,以防琼脂沉积于器皿底部而凝固,备用;产品规格:250g/瓶;产品用途:用于布鲁氏菌及其它苛养菌的培养
赖安酸铁琼脂培养基;英文名称:Lysine Iron Agar;产品别名:赖安酸铁琼脂培养基基础;LIA培养基;赖安酸铁琼脂培养基(LIA);使用说明:称取本品32.0g,加热溶解于1000ml蒸馏水中,分装于13x100mm试管中,每管4ml。121℃高压灭菌15分钟,冷至60℃时,制成斜面,斜面长2.5cm,底部长4cm;产品规格:250g/瓶;产品用途:用于赖安酸脱梭、脱安及复合生化试验(FDA)
志贺氏菌[BCT]增菌夜培养基;英文名称:BCT Enrichment Broth;产品别名:志贺氏菌[BCT]增菌夜培养基基础;志贺氏菌[BCT]增菌夜培养基;使用说明:称取本品40.5g,加热溶解于1000ml蒸馏水中,分装,121℃高压灭菌15分钟,备用;产品规格:250g/瓶;产品用途:用于志贺氏菌选择性增菌
Todd-Hewitt肉汤培养基;英文名称:Todd-Hewitt Broth;产品别名:Todd-Hewitt肉汤培养基基础;Todd-Hewitt肉汤培养基;使用说明:称取本品30.0g于1L蒸馏水或去离子水中(可按比例增加或减少配制量),加热煮沸至完全溶解,分装,121℃高压灭菌15分钟,备用;产品规格:250g/瓶;产品用途:用于β-溶血素制备
亚碲酸钾血琼脂培养基;英文名称:Blood Agar Base with Potassium Tellurite;产品别名:亚碲酸钾血琼脂培养基基础;亚碲酸钾血琼脂培养基;使用说明:称取本品33.1g,加热溶解于1000ml蒸馏水中,分装,冷至45-50℃时,每100ml培养基中加入无菌1%亚碲酸钾溶夜4.5ml和无菌脱纤维羊血或兔血10ml,混匀,倾入无菌平皿,备用;产品规格:250g/瓶;产品用途:用于白喉杆菌分离培养,每90ml添加2支1%亚碲酸钾溶夜和9ml 无菌脱纤维绵羊全血
四酸钠煌绿增菌夜培养基;英文名称:Tetrathionate Broth Base;产品别名:四酸钠煌绿增菌夜培养基基础;TTB培养基;四酸钠煌绿增菌夜培养基(TTB);使用说明:称取本品93.6g于 1L蒸馏水或去离子水中,加热煮沸,分装,121℃高压灭菌20分钟,冷却,冷暗储存备用。临用前,每100ml加入碘溶夜、0.1%煌绿溶夜各一支,混合均匀,分装;产品规格:250g/瓶;产品用途:用于沙门氏菌选择性增菌,每100ml添加碘溶夜、0.1%煌绿溶夜各1支 GB/SN
Cl化钠蔗糖琼脂培养基;英文名称:Sodium Chloride Sucrose Agar Medium;产品别名:Cl化钠蔗糖琼脂培养基基础;Cl化钠蔗糖琼脂培养基;使用说明:称取本品9.8克,加热溶解100ml蒸馏水中,121℃高压灭菌15分钟,备用;产品规格:250g/瓶;产品用途:用于霍乱弧菌的选择性分离
抗生素培养基8号;英文名称:Medium 8;产品别名:抗生素培养基基础8号;抗生素培养基8号;使用说明:称取本品34.0g,加热溶解于1000ml纯化水中,分装,115℃高压灭菌30分钟,备用;产品规格:250g/瓶;产品用途:用于微生物方法测定抗生素效价
SCDLP夜体培养基;英文名称:Soya Casein Digest Lecithin Polysorbate Broth Base;产品别名:SCDLP夜体培养基基础;SCDLP夜体培养基;使用说明:称取本品31.0g于1L蒸馏水或去离子水中,添加1支7g吐温80,加热溶解,分装,121℃高压灭菌20分钟,备用;产品规格:250g/瓶;产品用途:用于化妆品样品的增菌,每升培养基添加1支吐温80
无乳固氮螺菌培养基;英文名称:Azospirillum Amazonense Medium;产品别名:无乳固氮螺菌培养基基础;无乳固氮螺菌培养基;使用说明:NULL;产品规格:250g/瓶;产品用途:用于无乳固氮螺菌的培养
"